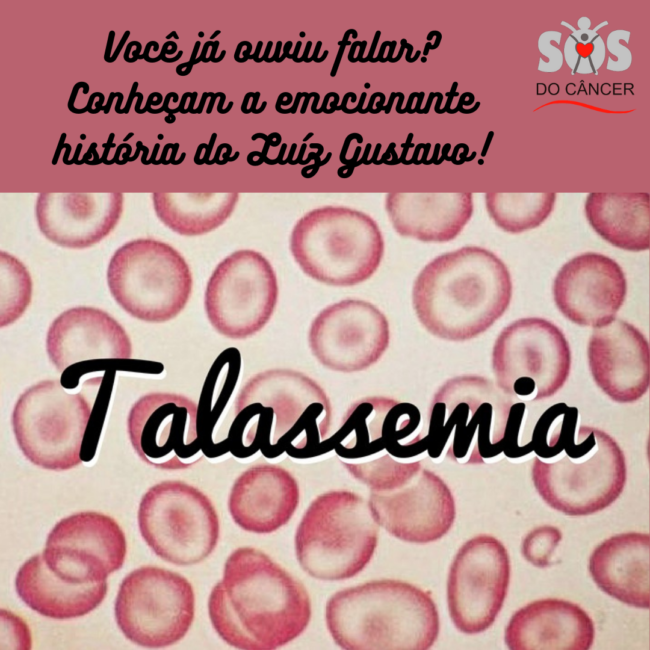

Conheçam a valente Marlene!
A SOS do Câncer luta diariamente para levar esperança de cura e principalmente para dar dignidade aos seus pacientes. Dona Marlene é paciente da SOS do Câncer. Ela já enfrentou o Câncer de Mama e agora trava uma nova batalha! Seja você também um parceiro da Vida! Ajude a SOS do Câncer a salvar vidas!